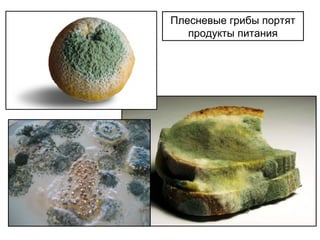
Плесневые грибы портят
продукты питания

Грибы могут как вредить, так и приносить пользу. Они разрушают продукты, вызывают заболевания у растений и людей, но также участвуют в разложении органики и производстве антибиотиков. Некоторые грибы съедобны и используются в пищевой промышленности, в то время как другие являются ядовитыми.